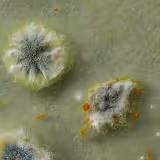

- A trained phlebotomist will guide you through the process.
- A tourniquet is placed on your arm, the site is cleaned, and a small needle is used to collect blood into one or more tubes.
- Results are usually ready in about a week.
- Most people feel only a quick pinch.
- The needle is removed, gentle pressure is applied, and a bandage is placed.
100+ lab tests. Every year. Detect early signs of 1,000+ conditions. All for only $199




Join Shaan’s 20/20 Challenge

How it works
Test your body with Superpower
100+ biomarkers across energy, hormones, longvity & more
Follow your personalized plan
Receive tailored actions on diet, supplements, and recovery
Re-test in ~90 days
Track your biological age, strength, and mental clarity
Compete for “Most Impoved”
The leaderboard ranks biological age gains — by effort, not luck.
Join anytime before January 1 2026. Don’t wait for New Year’s resolutions — your transformation starts now.
The winner earns a $10,000 Superpower Health Package, including:

$199 Premium health membership
From heart health to hormone balance, our comprehensive test panels detect early signs of over 1,000 conditions.
.avif)

What you get with
Superpower in 10 days

Test your whole body
Get a comprehensive blood draw at one of our 2,000+ partner labs or from the comfort of your own home.

An Actionable Plan
Easy to understand results & a clear action plan with tailored recommendations on diet, lifestyle changes, supplements and pharmaceuticals.

A Connected Ecosystem
You can book additional diagnostics, buy curated supplements for 20% off & pharmaceuticals within your Superpower dashboard.
What’s also included in your blood test

All your data in one place
100+ labs, your biological age & health report.

Upload past lab data
Visualize past Quest or Labcorp results.
.avif)
Your personalized health plan
Lifestyle, diet, supplement & Rx recommendations.

Unlimited concierge messaging
Ask unlimited questions and get answers within 24 hours on week days from our care team.

Add-on testing anytime
Advanced gut microbiome, toxins & cancer screens.

Access to Superpower Clinic
Curated solutions available after medical evaluation.
membership
$17

.avif)
.avif)

Superpower
Membership
.avif)
"Going through this process made me feel like it was a no brainer of an investment, rather than playing guesswork with my health"
.avif)
Frequently Asked Questions
Read more- Drink plenty of water beforehand — hydration makes veins easier to find.
- Wear loose sleeves so your arm is easy to access.
- Follow any fasting instructions you’ve been given.
- Let us know if you’re on medications, have fainted before, or have needle anxiety.
- Press gently on the site for a few minutes.
- Keep the bandage on for 4-6 hours.
- Skip heavy lifting or strenuous exercise for the rest of the day.
- Drink extra water to rehydrate.
- Monitor the site for redness, swelling, or pain.
Your membership includes:
- An annual full body test and report across 100+ biomarkers
- A personalized action plan to optimize your biomarkers and reach your health goals
- A dashboard to centralize your health data and track changes across a lifetime
- Access to a health concierge for questions on your plan and help scheduling
- Plus a marketplace of curated health products and services cheaper than amazon
Many concierge clinics charge $10k – $100k for their services, we’ve built technology to make the world’s best healthcare as accessible as possible via an all-in-one membership.
- Alabama
- Arizona
- California
- Colorado
- Connecticut
- Delaware
- District of Columbia
- Florida
- Georgia
- Idaho
- Illinois
- Indiana
- Kansas
- Maine
- Maryland
- Massachusetts
- Michigan
- Minnesota
- Missouri
- Montana
- Nebraska
- Nevada
- New Hampshire
- New Jersey
- New Mexico
- New York
- North Carolina
- Ohio
- Oklahoma
- Oregon
- Pennsylvania
- South Carolina
- Tennessee
- Texas
- Utah
- Vermont
- Virginia
- Washington
- West Virginia
- Wisconsin
- Kentucky
- Iowa
Superpower specializes in prevention-based testing and treatments and is not intended for emergency or immediate health issues.
While you will have a Superpower care team, your annual membership is designed to complement a primary care doctor if you have one, not replace them.
We are happy to help you share any test results with an outside provider to ensure you receive well-rounded medical care.
Your annual lab test panel takes about a week to process. We will text you as soon as they become available in your dashboard. Other types of tests may have different testing windows. The Superpower concierge is your own health assistant who helps answer your questions on your results, ensure smooth scheduling, coordination of any office-based tests and navigating you to interface with your care team.
Superpower membership and products are all eligible for HSA/FSA funding.
We see Superpower like a gym membership for those committed to prevention and performance. Superpower is a bridge between wellness and healthcare. Health insurance traditionally focuses on reactive care whereas, at Superpower, we believe it’s never too early to start looking out for your long-term health.
Absolutely — you're not limited to just one. Your membership includes one comprehensive 100+ biomarker blood test each year, but if you'd like to track your progress more closely, you can add extra tests at any time. Each additional full-panel test come at an additional cost. You can order as many as you'd like throughout the year.




.avif)